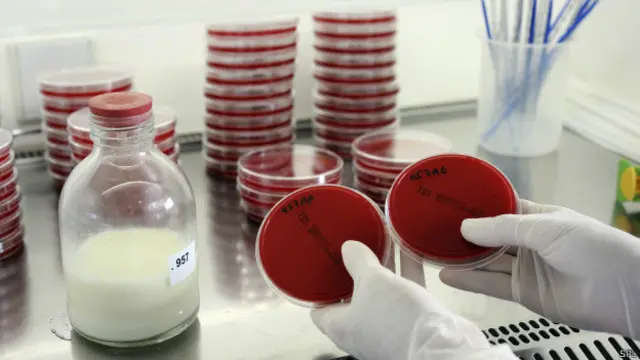
ASI yang dijual di dunia maya sering tidak terpasteurisasi sehingga peminumnya terancam terpapar hepatitis B dan C, HIV serta sifilis.

Peneliti ingatkan bahaya ASI yang dijual di dunia maya

Sumber gambar, .
Air susu ibu (ASI) yang dijual di dunia maya dan sering dibeli oleh berbagai kalangan, seperti binaragawan dan pasien kanker, berbahaya bagi kesehatan, menurut para peneliti di Inggris.
Praktik jual-beli ASI secara daring atau online akhir-akhir ini dapat dijumpai di situs-situs khusus serta grup-grup jejaring sosial.
Belum jelas berapa banyak ASI yang diperdagangkan karena transaksi antara penjual dan pembeli berlangsung secara tertutup.
Dr Sarah Steele, dari Barts and the London School of Medicine and Dentistry, mengatakan kepada BBC bahwa perdagangan ASI menunjukkan “pertumbuhan konsisten di seluruh dunia”.
Namun, menurut Steele, maraknya perdagangan ASI tidak dibarengi dengan tingkat higienis yang memadai.
Melalui sebuah kajian yang dilakoni Steele dan tim peneliti dari Queen Mary University of London, 93% ASI yang dijual secara daring mengandung tingkat bakteria yang terdeteksi karena biasanya susu itu dipompa atau disimpan menggunakan peralatan yang tidak steril.
Akibatnya, jika ASI itu dikonsumsi, peminumnya terancam terpapar hepatitis B dan C, HIV serta sifilis.
Adapun klaim-klaim yang mengatakan ASI tersebut bisa mendongkrak sistem kekebalan tubuh, menurut para peneliti, menyesatkan dan bisa membahayakan peminumnya.
Sumber gambar, SPL
Standar keamanan
Steele mengatakan ASI yang dijual secara daring tidak memiliki standar keamanan yang telah diuji seperti makanan lainnya.
Dia khususnya mengkhawatirkan pasien-pasien kanker yang mengonsumsi ASI tersebut.
“Bagi pasien kanker dan pasien lainnya dengan kekebalan tubuh yang rendah, sistem imun mereka tidak berfungsi dengan baik layaknya pada seseorang yang sehat. ASI ini diiklankan memiliki maafat bagi kekebalan, namun sebenarnya itu membawa ancaman, dan tubuh anda terekspos pada bakteri dan virus yang bisa berbahaya bagi kondisi medis anda,” kata Steele yang turut menyusun laporan kajian ASI yang diterbitkan Journal of the Royal Society of Medicine.
ASI yang beredar di dunia maya awalnya bertujuan untuk membantu para perempuan yang tidak memproduksi cukup ASI.
Namun, ASI itu juga dibeli oleh orang-orang yang berniat membentuk otot serta enggemar makanan yang dipanggil “foodies”.
Salah satu situs yang menjual ASI, onlythebreast.com, mengatakan pada BBC bahwa mereka menyarakan semua pembeli mempasteurisasi susu dulu sebelum menggunakannya.
Pengelola situs itu mengklaim kebanyakan penjual ASI yang mereka fasilitasi adalah orang-orang jujur yang “hanya ingin memberikan ASI yang aman bagi bayi-bayi yang membutuhkannya”.
Seorang perwakilan dari situs itu menambahkan: “Mereka yang melakukan penelitian itu tidak mengikuti petunjuk keamanan kami, yang mungkin mempengaruhi hasil studi.”



























